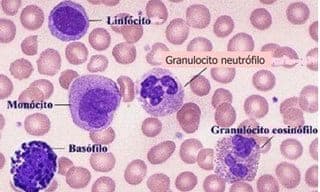

Sistema Nervioso
Introducción
Los sistemas modernos de producción exponen a los animales a ambientes más estresantes que cuando éstos son criados libremente, y a pensar de que se trata de minimizar el estrés en los animales, en la mayoría de éstos, el estrés se refleja en los perfiles endocrinos lo cual trae como consecuencia cambios en el comportamiento del animal y consecuentemente puede reflejarse en cambios negativos de la calidad de la carne (Alarcón y col., 2008). Un "estresor" es cualquier cambio medioambiental que rompe la homeostasis (Squires, 2003). El concepto de homeostasisse puede definir como un estado estable obtenido por la interacción óptima de los procesos que realiza el animal (Llamas et al., 2006b). Los sistemas fisiológicos que mantienen una homeostasis y que se activan cuando se necesitan regular las funciones, son los niveles de glucosa en la sangre, los niveles de pH y la temperatura. El tipo de intensidad y duración del estrés son determinantes importantes en la respuesta de un organismo, el intervalo de estrés es un factor importante en la habilidad de un individuo a habituarse al estrés (Alarcón y col., 2008).
La respuesta a los estresores requiere una progresión de eventos que empiezan con darse cuenta y señalización de varios mecanismos biológicos que una amenaza existe en el individuo. Estos eventos se siguen por la activación de mecanismos neurofisiológicos para aumentar un esfuerzo biológico para resistir y prevenir un daño mayor. Los varios detectores sensoriales no sólo reciben la información, también transforman esa información en signos nerviosos que se transmiten a cualquiera de los centros cognoscitivos (capacidad de comprensión) y no cognoscitivos del sistema nervioso para generar una respuesta coordinada al desafío (von Borell, 2001).
El sistema nervioso central (CNS), sistema inmunológico, y el sistema endocrino actúan recíprocamente, responde a los estímulos opresivos de una manera coordinada, e influye en la conducta del animal (Figura 1) (von Borell, 2001; Llamas et al, 2006b). A esta interacción para su estudio se le dio el termino neuroinmunoendocrinologia(Llamas et al., 2006b). Estos tres sistemas tienen influencias regulatorias y bidireccionales, la existencia de esas interacciones están soportadas por evidencia que las citoquinas, péptidos hormonales y neurotransmisores, y sus receptores son endógenos al cerebro, endocrino y sistema inmune (von Borell, 2001; Llamas et al, 2006b).

Figure 1. La comunicación entre el sistema nervioso central (CNS), sistemas endocrinos, y sistema inmunológico. CRH = hormona liberadora de corticotropina. Fuente: von Borell, (2001).
Comunicación neuroinmunoendocrina
El sistema inmunitario se considera actualmente un sistema regulador del organismo que trabaja en todo momento en íntima comunicación con los otros sistemas reguladores, el nervioso y el endocrino. Se sabe que las células de los tres sistemas comparten receptores para los mediadores típicos de los otros y pueden sintetizar dichos mediadores. Así, en las células del sistema nervioso, en las del endocrino y en las inmunitarias hay receptores para neurotransmisores, hormonas y citoquinas, y en los tres se encuentran esos mediadores. De hecho los leucocitos producen neurotransmisores y hormonas y que las células nerviosas pueden producir citoquinas típicas de los leucocitos. Además, los mediadores neuroendocrinos afectan a la función inmunitaria, y las citoquinas modifican funciones nerviosas y endocrinas (de la Fuente, 2005).
Se ha indicado que el sistema inmunitario es el receptor corporal de los estímulos que se pueden denominar "no cognitivos", esto es, una infección, la malignización tumoral, etc. De igual manera, el sistema neuroendocrino lo es de los estímulos "cognitivos" como la luz, el sonido, etc. Cuando se recibe un tipo u otro de estímulo, cada sistema responde al suyo, pero también se lo comunica al otro. Esta comunicación se puede ejemplificar con una situación de estrés emocional. La situación de estrés es recibida por el sistema neuroendocrino, de modo que se activa el eje hipotálamo-hipófiso-adrenal y se liberan glucocorticoides, los cuales, además de preparar el organismo para esa situación, informa a las células inmunitarias de la misma, y estas células responden activando unas funciones e inhibiendo otras (de la Fuente, 2005).
El sistema nervioso y el sistema endocrino están conectados anatómica y funcionalmente con el sistema inmunitario. De hecho, todos los órganos inmunitarios y las diferentes localizaciones de las células del sistema defensivo se encuentran inervadas y por ello, los neurotransmisores pueden alcanzar a las células inmunitarias. Además, estas células circulan por la sangre o están en localizaciones irrigadas, pudiendo contactar con todo tipo de hormonas, mediadores que regulan la función inmunitaria (de la Fuente, 2005).
La regulación neuroendocrina que tiene el sistema inmunitario, se puede indicar que los efectos son activadores o inhibidores dependiendo del mediador, de su concentración, del estado de la célula inmunitaria, de su localización, etc. Se puede explicar la heterogeneidad de las respuestas funcionales del mismo, incluso entre sujetos de una misma población, ya que el estado emocional del individuo, la edad, la estación del año, el momento del día y toda otra serie de circunstancias, como el estado mental que se desarrolle, van a influir en el estado inmunitario que se manifieste (de la Fuente, 2005).
Sistema Nervioso
Este sistema constituye la vía de comunicación principal entre el organismo y el medio que lo rodea, a través de un conjunto de órganos altamente especializados que se encargan de mantener el equilibrio entre ambos. Además el metabolismo del propio organismo condiciona a su vez una serie de estímulo a los que también reacciona. En los organismos multicelulares superiores la relación entre la zona donde recae la excitación y el órgano que reacciona está a cargo del sistema nervioso (Richard y col., 1991).
El sistema nervioso está constituido por un conjunto de órganos altamente especializados que para su mejor estudio se divide en dos grupos que son: Sistema nervioso central (los principales componentes la médula espinal, cerebro y cerebelo)y Sistema nervioso autónomo o vegetativo (Richard y col., 1991).
Cerebro
Una de las principales funciones del cerebro es percibir los agentes estresantes, avisar del aviso y capacitar a un organismo para enfrentar las consecuencias (Alarcón y col., 2008). Los cambios en el cerebro pueden resultar en la respuesta a la liberación de las hormonas del estrés y a la consecuente activación de los receptores de glucocorticoides en las diferentes regiones cerebrales. Algunos aspectos de la función cerebral pueden temporalmente suprimirse para minimizar un daño a largo plazo, por ejemplo: por opiodes cuando hay un dolor severo, o afectándolo permanentemente, sí los retos son excesivos por ejemplo: en ambientes severamente empobrecidos. Algunos de los sistemas activados durante situaciones estresantes pueden conferir "protección" a las células del cerebro. Una sobrecarga de los sistemas de habilidad puede llevar a una lesión cerebral, daño a las neuronas del hipocampo, remodelación de las dendritas en el hipocampo u otra desorganización cerebral (Zanella y Broom, 2003). Las medidas cerebrales, acelera los reflejos (Alarcón y col., 2008), incluyen las tareas cognitivas, los cambios morfológicos, la expresión de genes (Zanella y Broom, 2003), aumenta la tolerancia al dolor, disminuye el apetito y la actividad sexual e inhibe la inflamación mediada por el sistema inmune. Esta serie de reactividades del estrés se completan a través de la liberación de neurotransmisores y hormonas como respuesta al estrés (Alarcón y col., 2008).
Lo anterior pueden explicar posiblemente la naturaleza y la magnitud de los efectos del bienestar de los animales (Zanella y Broom, 2003). El sistema del límbico del cerebro incluye las estructuras como el hipotálamo (control endocrino), núcleo tálamico, amígdala, e hipocampo (Figura 2) (von Borell, 2001).

Figura 2. Sistema límbico, Fuente: Swing et al, (1999); citado por von Borell, (2001). El cerebro es el iniciador y el órgano regulador de la respuesta del estrés, y también tiene el papel de la integración interna y externa de señales neurosensoriales. Las respuestas al estrés involucran la activación de los nervios (central y autonómica), endocrino y sistema inmune. La interacción entre estos 3 sistemas van a regular y determinar el resultado de las respuestas del estrés (Figura 3). Las respuestas del estrés pueden ser activadas durante respuestas a inflamaciones e infecciones. Sin embargo el cerebro debe ser informado de cuando ocurrieron los eventos en la periferia. Durante infecciones o inflamaciones, células del sistema inmune, principalmente neutrófilos y macrófagos, quedan activados. Los macrófagos periféricos interactúan con el cerebro produciendo citoquinas, que son considerados como hormonas del sistema inmune. Las funciones del sistema inmune sirven como un órgano sensitivo que difunde señales al cerebro sobre eventos que ocurren en la periferia (Llamas et al., 2006b).

Figura 3. Interacción entre los sistemas nervioso, endocrino e inmune. Fuente: Llamas et al, (2006b).
Sistema nervioso vegetativo o autónomo
Es el encargado de regular importantes funciones vitales como la digestión, respiración, metabolismo, secreción, temperatura corporal, equilibrio hídrico, etc., es decir, lo que ocurre independientemente de la voluntad o la conciencia del individuo. En la regulación y coordinación de estas funciones también interviene el sistema endocrino (Richard y col., 1991).
Las neuronas motoras eferentes llevan la información al sistema nervioso central, pueden ser divididas en dos sistemas principales, el sistema somático o voluntario que controla los movimientos voluntarios del músculo esquelético, y sistema autonómico que controla músculo liso y cardíaco y varias glándulas. Las neuronas del sistema nervioso autónomo pertenecen a ambos el simpático o vía parasimpático que generalmente actúan en oposición a cada otro. Las neuronas de la vía parasimpático contacta los órganos designado vía receptores colinérgicos que usan la acetil colina como el neurotransmisor. Las neuronas simpáticas usan la noradrenalina como el neurotransmisor a los órganos designados y así tienen los receptores adrenérgicos. Hay dos tipos de receptores los adrenérgicos, los a-receptores, que se bloquean selectivamente por la droga fenoxibenzamina, y β-receptores que se bloquean por propanolol (Squires, 2003).
El sistema simpático y el parasimpático actúan en oposición entre si, con el equilibrio entre estos dos sistemas que regulan los sistemas del cuerpo (Squires, 2003). Las actividades parasimpáticas son antagonistas (opuestas) a por actividades simpáticas que movilizan la energía durante el estrés (von Borell, 2001). El sistema parasimpático predomina en un estado relajado baja el ritmo cardiaco y mantiene las funciones como la digestión. Cuando el animal es amenazado, la vía simpática predomina (Figura 4) (Squires, 2003).

Figura 4. Sistema simpático y el parasimpático, Fuente: MicrosoftLas hormonas de la médula adrenal, conocidas como "catecolaminas", pertenecen a la clase química de las aminas y se denominan epinefrina (adrenalina) (Hafez, 1996; von Borell, 2001; Squires, 2003), la región de ceruleus de sitio en el diencefálico contiene fibras nerviosas que secretan norepinefrina (noradrenalina) (LUC-NE) y también se estimula por el estrés (Figura 5) (Squires, 2003).

Figura 5. Respuesta del sistema nerviosa simpático al estrés. Fuente: Squires, (2003).En el cuerpo la norepinefrina se forma por células nerviosas y la epinefrina se forma en la médula suprarrenal (Figura 6). La norepinefrina transmite información de una célula nerviosa a otras células, mientras que la médula suprarrenal es el centro de una glándula endocrina llamada glándula suprarrenal (Alarcón y col., 2008).

Figura 6. Esquema de la glándula suprarrenal y sus tipos de células. Fuente: Gartner y Hiatt, (2001).La adrenalina y noradrenalina inhiben el almacenamiento de glucosa y ácidos grasos, inhiben la síntesis de proteína y estimulan la liberación de glucosa, aminoácidos y ácidos grasos libres del músculo, tejido graso e hígado. El ritmo cardiaco se incrementa, con el flujo sanguíneo redistribuido a los músculos cardiacos y esqueléticos, y el proceso anabólico, como la digestión, crecimiento, reproducción y función inmune, se suprimen (Squires, 2003). Ésta es una respuesta hormonal rápida que ocurre en segundos para apoyar el animal en el síndrome de "huída o lucha" o FFS (Squires, 2003; Tolleson, 2007). La proporción entre la actividad simpático y la parasimpático determina si un animal está en un estado de excitación física o psicológica o relajación (von Borell, 2001).
Las catecolaminas presentan, a través de mecanismos de regulación vegetativa y estimulación metabólica, un efecto negativo sobre la calidad de la carne resultante ya que por efecto de la adrenalina y noradrenalina se produce un aumento del ritmo cardiaco con un incremento en la presión sanguínea y mayor circulación sanguínea en el músculo debido a vasodilatación en los músculos y paralelamente una vasoconstricción periférica. Estos procesos pueden estar relacionados con la formación de pequeñas hemorragias y petequias, en la musculatura, la adrenalina a través de la activación de sistemas enzimáticos, provoca un aumento en la degradación de glucosa muscular a ácido láctico, lo que después del desangrado origina un acelerado descenso de pH en la musculatura debido a la ausencia de la función buffer y transporte de la sangre (Alarcón y col., 2008).
Sistema Inmune (parte 2)
Introducción
Esta bien establecido y aceptado hoy en día la existencia de la interacción bidireccional entre el SNC y el sistema inmune. Además la interacción entre el SNC y el sistema inmune pueden tener efectos sobre la inmunoregulacion, el SNC controla acciones neuroendocrinas y en general el metabolismo del huésped. El sistema inmune se comunica con el cerebro, recibiendo señales vía en sistema nervioso autónomo. En turno la información se regresa al cerebro vía citoquinas. En adición el SNC pueden regular indirectamente el sistema inmune vía el sistema neuroendocrino (eje HPA) y secreción hormonal de péptidos. La interacción del sistema nervioso autónomo y el sistema inmune fueron inicialmente mostrada por la existencia de la innervación directa primaria (timo y médula ósea) y secundariamente (bazo y nódulos linfáticos) órganos inmunes. La innervación del timo y la barrera hematocefálica regulan el desarrollo de células T y células B respectivamente. Es posible que la activación del sistema nervioso simpático durante la respuesta inmune puede ser dirigido a localizarse la respuesta de inflamación vía inducción de la acumulación neutrofila y la estimulación de respuestas inmune humoral mas especificas. En general este grupo de conexiones del nervio periférico, cascadas hormonales e interacciones celulares permiten el SNC a regular el sistema inmune local en sitios de inflamación, regionalmente en órganos inmunes, y sistemáticamente en las rutas hormonales (Llamas et al., 2006b).
Sistema inmune y estrés
Se establece bien que los animales criados en ambientes dónde son expuestos a un alto número de patógenos, no comen bien, su crecimiento no es bueno, incluso cuando ninguna enfermedad clínicamente identificable está presente (Johnson et al., 2001). A lo largo de su vida los cerdos están continuamente expuestos a agresiones patológicas fruto de las condiciones sanitarias, de manejo, de alojamiento y de alimentación, ante esta agresión el organismo responde con un mecanismo complejo en que diferentes medios colaboran para su defensa (Santomá y Pontes, 2006).
Sin embargo no todos los estresores provocan las mismas reacciones (Cisneros, 1999; 2000), los sistemas nervioso e inmunitario del cerdo interactúan de forma compleja; el estrés físico, visual, emocional (Harris, 2000), además de los procesos infecciosos que son iniciados por la exposición de animales a los patógenos (es decir, bacteria, virus) o no patógenos (por ejemplo, endotoxinas) (Williams et al., 1997), complejos inmunes, toxinas, daño físico, y una variedad de procesos inflamatorios (Nazará, 1996), los resultados de los antígenos en la liberación de citoquinas (Williams et al., 1997).
Las respuestas del estrés pueden ser activadas durante respuestas a inflamaciones e infecciones. Sin embargo el cerebro debe ser informado de cuando ocurrieron los eventos en la periferia. Durante infecciones o inflamaciones, células del sistema inmune, principalmente neutrófilos y macrófagos, quedan activados. Los macrófagos periféricos interactúan con el cerebro produciendo citoquinas, que son considerados como hormonas del sistema inmune. Las funciones del sistema inmune sirven como un órgano sensitivo que difunde señales al cerebro sobre eventos que ocurren en la periferia (Llamas et al., 2006b).
El estrés esta conocido por inducir neutrofilia (aumento de leucocitos neutrófilos en la sangre o en los tejidos) y linfopenia (reducción en el número de linfocitos) y esto resulta en un incremento en la proporción de neutrófilos a linfocitos (N:L). El incremento en la proporción N:L a sido encontrados en cerdos expuestos al estrés del transporte, destete y con el incremento del tiempo a la matanza (Llamas et al., 2006b).
Lipopolisacaridos (LPS)
Lipopolisacárido (LPS), son componentes intrínsicos de la membrana de las bacterias gram negativas (Llamas et al., 2006a; Collado y col., 2008a), tales como Salmonella o Escherichia coli (Collado y col., 2008a), ha sido frecuentemente usado como un modelo para estudiar las interacciones neuroendocrina-inmuno en los cerdos. Los LPS provocan en síntesis la liberación de citoquinas por los macrófagos y neutrófilos. Las citoquinas TNF-a, interleuquina-1 (IL-1) interleuquina-6 (IL-6) tienen la capacidad de activar las respuestas de la fase aguda y van hacerlo por la inducción de hepatocitos para sintetizar las proteínas de la fase aguda como la C-reactiva (CRP), suero amiloide (SAA) y haptoglobina (Hp). Los LPS también activan el eje hipotálamo-pituitario-adrenal (HPA) vía estimulación citoquinas pro-inflamatorias, resultando en el aumento de secreciones de glucocorticoides. La respuesta de las citoquinas pro-inflamatorias y varias proteínas de la fase aguda para la administración de LPS en los cerdos ha sido reportada en varias publicaciones donde había el uso de altas dosis de LPS (de 25 a 100 µg/kg de peso vivo de LPS) (Llamas et al., 2006a).
Sistema inmune
Los seres vivos superiores defienden constantemente su integridad biológica frente a agresiones, procedentes tanto del exterior como del interior del propio organismo, gracias a que disponen de un conjunto de órganos, células y moléculas, conocido como sistema inmune. El sistema inmune es capaz de elaborar dos tipos de respuesta: la respuesta inmune innata, también llamada natural o noespecífica, y la respuesta inmune adquirida, también conocida como adaptativa o específica (Collado y col., 2008b).
Los mecanismos dispuestos al sistema inmune pueden ser: 1) no específico, tiene la habilidad de reaccionar previamente sin estar expuesto a los antígenos, directamente a los agentes extraños en general y; 2) los mecanismos de defensa específicos, activados por el organismo particularmente cuando ha sido expuesto previamente.
Las primeras defensas con las que se enfrentan los agentes externos al intentar penetrar en el organismo son totalmente inespecíficas y están constituidas por las barreras anatómicas, de índole física, química o biológica características de cada localización, mientras que algunas, como la temperatura, son sistemáticas (Figura 7). Entre todas conforman la inmunidad innata, y aunque se la denomina inespecífica, algunas de sus elementos son capaces de discriminar lo propio de lo ajeno y actuar de forma rápida frente a los segundos. La importancia de estas barreras está reflejada en la facilidad con la que se adquieren infecciones cuando falla alguna de ellas (Collado y col., 2008a).

Figura 7. Defensa innatas de los animales. Con letras azules se identifican los mecanismos sistémicos, y en letras negras, los locales. "Sudor" el cerdo aunque está provisto de glándulas apócrifas cutáneas, el cerdo no suda; su tolerancia al calor es deficiente, excepto si tiene la posibilidad de humedecer su revestimiento cutáneo, para aumentar así sus pérdidas por evaporación. Modificado de Collado y col, (2008a).
Mecanismos y elementos que componen la inmunidad innata
La respuesta innata requiere la actuación de varios mecanismos y elementos (Figura 8):
1.- Barreras físicas, químicas y biológicas: tales como, la piel y las mucosas, diferentes enzimas de secreciones corporales (lisozima, lactoperoxidasa, etc.) y la microbiota autóctona (intestinal, vaginal, etc.), correspondiente a cada órgano o sistema.
2.- Factores solubles: cuyos principales componentes son el complemento, las proteínas de inflamación y las citoquinas.
3.- Células: incluyendo, las células fagocíticas, tanto polimorfonucleares (neutrófilos, eosinófilos y basófilos), como mononucleares (macrófagos y células dendríticas), y células asesinas: K (Killer), NK (natural killer) y LAK (lymphokine activated killer) (Collado y col., 2008a; Doménech y col., 2008).

Figura 8. Mecanismos externos e internos de la inmunidad innata y principales elementos. Fuente: Collado y col, (2008a).Las barreras externas (físicas, químicas y biológicas) actúan, todas ellas, de forma constante como primer nivel de defensa, impidiendo la entrada de los microorganismos hacia el interior del organismo y su proliferación. En el supuesto que el agente extraño supere estas barreras se producen la activación de los mecanismos innatos internos (factores solubles y el componente celular) tratando de evitar su establecimiento, desarrollo y acción patógena (Collado y col., 2008a).
Células de la inmunidad innata
Leucocitos
Los leucocitos mononucleares están representados por los monocitosy macrófagos. Los macrófagos derivan de los monocitos sanguíneos circulantes que migran en los tejidos en los que maduran. Están distribuidos por todo el organismo animal bajos distintos nombres según su localización (Figura 9) (Porras y col., 2008).

Figura 9. Maduración de los fagocitos mononucleares. Fuente: Romero, (¿?).Los macrófagos son originados del hueso y pueden diferenciar a los monocitos cuando están entre la circulación, donde pueden quedar por 1 o 2 días. Subsecuentemente, los monocitos emigran a todos los tejidos del cuerpo en donde pueden diferenciar a las distintas morfologías, antígenos y fenotipos funcionales. Así se llaman dependiendo de ubicación, como las células microglias o microgliales que se encuentran en el cerebro y en el sistema nervioso. Células de Kupffer que se encuentran en el hígado y macrófagos peritoneales que se encuentran en la cavidad serosa, entre otras (Cuadro 1) (Llamas et al., 2006b).
Fuente: Romero, (¿?).
Todos los macrófagos tienen la capacidad de las mismas actividades como fue descritos para los neutrófilos y en adición tienen habilidad de procesar y presentan antígenos a los linfocitos T (Llamas et al., 2006b).
Su vida media es más prolongada que los neutrófilos y tienen mayor repetida capacidad fagocítica. Los macrófagos son además células especializadas en la presentación de antígenos a los linfocitos T, iniciando así la respuesta inmune adaptativa (Porras y col., 2008).
Los leucocitos polimorfonucleares o granulocitos incluyen a neutrófilos, basófilos y eosinófilos. Los más importantes en la inmunidad innata son los neutrófilos ya que son las primeras células fagocíticas en acudir a un foco de infección, aunque decaen rápidamente y no tienen capacidad fagocítica repetida (Figura 10) (Porras y col., 2008).

Figura 10. Leucocitos. Fuente: Romero, (¿?).Los neutrófilos son producidos en el hueso y son enviados a la sangre, en donde van a tener una vida media aproximadamente 8 h (Llamas et al., 2006b), y en tejido 4 días (Romero, ¿?), la función principal de los neutrófilos es fagocitar y destruir los microorganismos extraños (Llamas et al., 2006b).
Células NK
Las células NK o asesinas naturales (natural killer), parecidas a los linfocitos en su morfología pero más grandes y con gránulos, causan la lisis de las células infectadas por microorganismos como los virus (Porras y col., 2008).
Las células NK son células linfoides tienen la habilidad de citotoxicidad natural y, consecuentemente se pueden matar a las variedades de células nucleótidas sin la previa estimulación al antigénico. La citotoxicidad de NK es alteranda en el cerdo, dependiendo de su estatus social después del transporte y estrés térmico (Llamas et al., 2006b).
Linfocitos
Existen dos tipos especiales de linfocitos T y B que, por tener receptores poco específicos, se considera que funcionan como parte del sistema inmunitario. Los linfocitos Tgd de la epidermis de la piel y del epitelio de las mucosas son capaces de reconocer ciertos patógenos y eliminar células epiteliales infectadas (Porras y col., 2008).
Los linfocitos B-1 sintetizan los llamados "anticuerpos naturales" que se encuentran circulantes en el organismo previo a una infección, y que son específicos frente a moléculas lipídicas y polisacáridos (LPS) que se comparten muchas bacterias (Porras y col., 2008).
Funciones
Las funciones principales de las células de la inmunidad innata son:
La fagocitosis (por neutrófilos y macrófagos), mediante la que reconocen, se unen engloban y destruyen elementos extraños. Esta función se ve favorecida por el recubrimiento de los microorganismos por moléculas de complemento o por anticuerpos lo que se denomina opsonización) que se unen a los receptores que tienen estas células en su superficie.
♦ La secreción de citoquinas y otras proteínas reguladoras de la respuesta inmune, en especial, por los macrófagos y las células NK.
Además intervienen en otros procesos relacionados con la respuesta adaptativa:
¨Varias células de la inmunidad innata (NK, neutrófilos, macrófagos) son capaces de unirse a los anticuerpos que recubren ciertas células gracias a un receptor (FcR) de su superficie, dando lugar a su lisis. Es el proceso denominado citotoxicidad celular dependiente de anticuerpos (ADCC).
¨Los macrófagos son capaces de procesar y presentar el antígeno que ingieren a las células responsables de la inmunidad adquirida, unido a sus moléculas de CMH de tipo II (Porras y col., 2008).
Factores solubles (complemento y citoquinas)
El complemento se compone de un gran número de proteínas plasmáticas que se van activando en cascada tras el reconocimiento de un microorganismo. Los componentes del complemento se encuentran inactivados en todos los fluidos del cuerpo y tejidos sin causar ningún efecto adverso. Sin embargo, en el sitio de infección se intensa, por lo que debe ser cuidadosamente regulado y controlado para evitar que cause más daño que beneficio (Porras y col., 2008).
Mecanismos internos del sistema inmune innato
Los mecanismos internos consisten en:
♦ La activación del complemento, la lisis directa del patógeno: con la formación de numerosos poros en su membrana, por acción de los últimos componentes de la cascada enzimática.
♦ El proceso da fagocitosis, facilitar la fagocitosis: un gran número de proteínas del complemento activadas se unen a los agentes patógenos, favoreciendo su ingestión por las células fagocíticas que expresan receptores para el complemento.
♦ La generación de una respuesta inflamatoria, inducir la inflamación: algunos fragmentos pequeños de las proteínas del complemento tras su activación actúan como factores quimiotácticos, reclutando más fagotitos al punto de infección.
Su acción suele comenzar con la activación y fijación del complemento a los agentes exógenos. Inmediatamente se inicia el proceso de fagocitosis, por el que se destruyen y eliminan los agentes extraños. Simultáneamente, las células fagocíticas producen señales químicas (citoquinas, tales como el factor de necrosis tumoral) y otros mediadores, que también inducen inflación. La inflamación a su vez, atrae y concentra nuevas células y moléculas en los lugares de invasión, intentando erradicar la infección y reparando los tejidos dañados (Figura 11) (Collado y col., 2008a).

Figura 11. Cascada de eventos que pone en marcha la inmunidad innata ante la llegada de un agente extraño. Como resultado de la activación del complemento tras la entrada de un microorganismo, se liberan moléculas que atraen a células implicadas en reacciones anafilácticas. La desgranulación de éstas provoca una serie de efectos por los que se concentran células en el lugar de activación del complemento, generando inflamación y favoreciendo la fagocitosis. Fuente: Collado y col, (2008a).
Inmunidad adquirida
La inmunidad específica o adquirida depende en la producción de linfocitos, la cual tiene memoria a un largo plazo, sobre reconocimiento del patógeno, generando una rápida y fuerte respuesta inmune. En este evento el sistema inmune del huésped responde produciendo anticuerpos (actividad hormonal) o linfocitos específicos que van cargando con receptores de anticuerpos sobre la superficie de las células (inmunidad de células intermedias). Los anticuerpos como inmunoglobulinas son producidas por linfocitos B, y pueden alcanzar su destino vía sanguínea, como el linfocito y el plasma de sangre. Por otro lado los linfocitos T son producidos en el timo y tienen la habilidad de la interacción directa con los antígenos (Llamas et al., 2006b).
Los linfocitos y células del plasma que se producen en los tejidos linfoide y están envuelto en las reacciones inmunes. Ellos están envueltos en la inmunidad adquirida (Figura 12), desde que la respuesta se dirige específicamente hacia agentes extraños que se refieren a la producción de anticuerpos por los linfocitos B, mientras que la inmunidad adquirida es llevada a cabo por los linfocitos T. Hay tres grupos de linfocitos células T, auxiliador las células de T, citotóxica las células de T y supresor las células T. El auxiliador las células de T (helper T cells Th) produzca linfoquinas (también conocido como citoquinas), qué son hormonas peptídicas que incluyen en las interleuquinas (IL) e interferones (IFN) un acto paracrina o manera autocrina para estimular otras células inmunes en el proceso de inflamación y las reacciones inmunes. Hay dos tipos de células de Th que son mutuamente inhibitorias. Las células Th-1 producen IL-2, IFN-g y TNF-β para promover inmunidad celular e inflamación. Las células de Th-1 se inhiben por IL-4 e IL-10, qué son citoquinas anti-inflamatorios mayores. Las células de Th-2 secretan IL-4, IL-10 e IL-13 para promover la inmunidad del humoral. Las células de Th-2 se inhiben por IL-12 e IFN-g que son citoquinas en pro-inflamatorios mayores. Así, los productos de células de TH-1 inhiben las células de TH-2 y viceversa. Las células T citotóxicas asesinas atacan y matan a los antígenos o células que se han sido invadidas por los virus. Las células supresoras T regulan las otras células para prevenir reacciones inmunes severas que podrían dañar a los propios tejidos del animal (Squires, 2003).

Figura 12. La inmunidad adquirida (tejido linfoide). Fuente: Squires, (2003).Por consiguiente, las células B y células T son responsables para la inmunidad adquirida y células mediaras de la inmunidad, respectivamente, qué se suma para formar la inmunidad innata (Cuadro 2) (Johnson et al., 2001).
Fuente: Johnson et al, (2001).
Inflamación
Reacción bioquímica y morfológica de los tejidos vivos en respuesta a la agresión de diferentes agentes, en la que se llevan a cabo de manera simultánea y consecutiva, una serie de eventos vasculares, celulares y humorales con el fin de eliminar el daño (Figura 13).

Figura 13. Inflamación, Fuente: Romero, (¿?).
Eventos celulares de la inflamación
◊ Marginación: Los leucocitos giran lentamente en el endotelio y momentáneamente se detienen.
◊ Pavimentación: Capas de leucocitos que se arreglan en la superficie del endotelio vascular.
◊ Emigración: El leucocito sale del vaso sanguíneo hacia el espacio perivascular.
◊ Quimiotaxis:
- Movimiento direccional de las células hacia un atrayente químico.
- Los leucocitos migran dependiendo del gradiente de quimioatracción.
- Los leucocitos fácilmente se deforman dependiendo de la estrechez del sitio de lesión.
- El leucocito repta hacia el sitio de inflación.
- Cambio de las características morfológicas de la célula incrementando la superficie de membrana (30 seg).
- Agregación de leucocitos transitoria y dependiendo de la dosis (pocos minutos).
- Orientación polarización durante la locomoción (lamelipodia, uropodo).
◊ Fagocitosis:
- Opsonización (favorece la fagocitosis)
- Contacto y reconocimiento
- Ingestión o engolfamiento
- Fagosoma
- Fagolisosoma
- Mecanismo microbicidas
- Expulsión de cuerpos residuales (Figura 14).
Figura 14. Respuesta inflamatoria aguda. Fuente: Romero, (¿?).
El período de bajo consumo de alimento después del destete también causa una respuesta inflamatoria en el tracto gastrointestinal que inicia en la función y respuesta inmune. Las investigaciones han demostrado que la expresión de los genes de las citoquinas pro-inflamatorias IL-1, IL-6 y TNF- α mRNA aumenta en los 2 días posteriores al destete, momento en que....